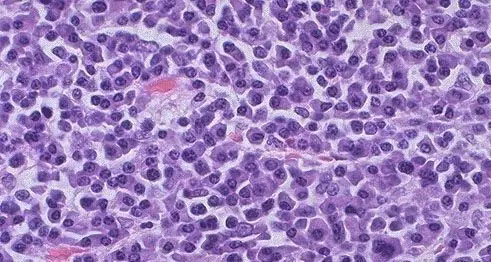
血液肿瘤的CAR-T治疗靶点点评集锦

CAR-T治疗的靶点选取至关重要
与已知的抗体药物相比——无论是传统的单克隆抗体药物(如赫赛汀,trastuzumab),抗体偶联药物(antibody drug conjugate, ADC, 如Kadcyla, ado-trastuzumab emtansine),还是双特异性抗体(如Blinatumomab)——CAR-T明显表现出对肿瘤细胞更强的靶向性和*伤杀**力。根据Dr. Carl June团队的报道和Eureka科研团队的研究,我们认为CAR-T可以有效杀死细胞表面抗原表达量较低的肿瘤细胞(拷贝数为几十到几百),而抗体介导的抗肿瘤药物只能杀死细胞表面抗原高表达的肿瘤细胞(拷贝数为几千到几万)。
临床数据显示,CAR-T细胞通过静脉回输患者体内后,除了聚集在肿瘤部位,也会进入肺部组织,进而在肝脏和脾脏聚集,最终分散到全身。在trastuzumab单链抗体介导的,以Her-2抗原为靶点的CAR-T临床试验中,由于正常肺组织血管内皮细胞低量表达Her-2,引发了病人快速的致死性的肺组织毒副反应。而单克隆抗体药物赫赛汀以及由trastuzumab介导的ADC药物Kadcyla临床使用则是相对安全的,没有关于肺组织致死性毒副作用的报道。
由于CAR-T疗法的高灵敏度,和传统抗体药物相比,其靶向/脱靶毒性会导致更为严重的毒副作用。因此,CAR-T治疗的靶点选取不能套用传统抗体治疗的靶点选取标准,而是需要寻找更为严格的肿瘤特异性抗原作为靶点。这篇概述总结归纳了已开展或即将开展的治疗血液肿瘤CAR-T临床试验中所选取的抗原靶点。
毋庸置疑,CAR-T最成功的案例是以CD19为靶点针对B细胞肿瘤的一系列临床试验。CD19广泛表达在多种B细胞恶性肿瘤细胞表面,在正常B细胞, 滤泡性树突状细胞表面也有表达,而在其他组织和血液细胞没有表达,血液中也未曾检测到CD19可溶性蛋白的存在。因此它被认为是CAR-T治疗B细胞肿瘤的理想靶点。临床试验结果显示,CD19 CAR-T对急性B-淋巴细胞白血病(B-ALL)的治愈率已经达到了90%。
除CD19 之外,还有哪些靶点被用于血液肿瘤的CAR-T治疗呢?

血液肿瘤CAR-T治疗靶点综述
一、B细胞恶性肿瘤
在B细胞恶性肿瘤治疗领域,除CD19外,还有另外几个B细胞特异性靶点,例如CD20, CD22 和B细胞膜结合的抗体轻链等。
CD20 CAR-T主要治疗B细胞非霍奇金淋巴瘤(B-NHL),例如韩为东教授带领的科研团队针对弥漫大B细胞淋巴瘤(DLBCL)进行的临床试验。
CD22 在急性B淋巴细胞白血病(B-ALL)和成熟淋巴细胞恶性肿瘤上均有高表达。对于CD19低表达或CD19分子丢失的B-ALL细胞来说,CD22 有希望成为CD19 在B-ALL上的替代靶点。CD22 CAR-T一期临床试验已显示出其安全性和临床有效性。
针对B细胞表面抗体轻链的CAR-T可用于治疗成熟B细胞肿瘤,同时避免了对发育早期阶段B细胞的攻击。临床前试验显示,这些CAR-T并不被血液中的可溶性抗体轻链中和。事实上,血液中的抗体轻链可以刺激和维持CAR-T细胞的增长。目前还没有其临床安全性和疗效的报道。
CD23和ROR1 是两个非B细胞系特异性的靶点,主要被用于慢性B淋巴细胞白血病 (B-CLL)治疗。CD23广泛表达于B-CLL肿瘤细胞,在正常组织主要存在于成熟B细胞,在一些单核细胞,T细胞,粒细胞以及小肠粘膜上皮组织也都有表达。慢性B淋巴细胞白血病(B-CLL)患者B细胞CD23的表达水平和血清sCD23(可溶性CD23)含量较正常人均显着升高,且血清sCD23含量与病情严重程度呈正相关。目前,CD23 CAR-T 主要集中在临床前的实验研究阶段。ROR1在B-CLL和套细胞淋巴瘤(MCL)中有高表达。正常脂肪组织及某些早期阶段的B细胞中有低量表达。ROR1 CAR-T治疗B-CLL的临床试验已经在德州大学安德森癌症中心(UT MD Anderson Cancer Center)开展,结果尚未报道。
二、急性髓细胞性白血病(Acute myeloid leukemia,AML)
复发性AML是死亡率极高的一类血液恶性肿瘤。急性髓细胞性白血病是髓系造血干/祖细胞恶性疾病,以骨髓与外周血中原始和幼稚髓性细胞异常增生为主要特征。针对AML的免疫治疗最大的挑战是寻找特异性的细胞表面靶点。目前在尝试的几个抗原都存在特异性不够高的问题。
CD123在白血病干细胞和白血病细胞表面高表达,但在正常造血干/祖细胞中低表达。虽然以CD123 为靶点的免疫毒素药物没有在患者体内显示出严重的造血干细胞毒性,但在美国希望之城国家医疗中心(City of Hope National Medical Center)开展的CD123 CAR-T临床试验中,预计会产生严重的造血干细胞毒性。控制造血干细胞毒性将是这项临床试验亟待解决的问题。
另一个AML的靶点——CD33,与CD123有相同的造血干细胞毒性问题。抗CD33的ADC药物 Gemtuzumab ozogamicin (Mylotarg) 在2010年因四期临床患者出现严重且可致命的肝静脉闭塞而撤市,但其后Pfizer在欧洲的临床试验显示,Mylotarg对不能化疗的老年病患有疗效,和一线化疗药物配合使用对部分人群也有显着疗效。Amgen的CD33-CD3 BiTE (AMG330)药物,在体外实验和动物模型里也显示出很好的疗效,但对于AMG330 在动物模型体内的毒副作用,未有详细描述。全球已有多个CD33 CAR-T项目的临床前试验报道,其中包括Dr. Carl June 团队使用Mylotarg scFv 制作的CAR-T。针对Mylotarg CAR-T治疗在动物模型试验中表现出的造血干细胞毒性,该团队提出了mRNA CAR-T 的应对方案。mRNA CAR-T 在动物模型里有显着疗效,同时和病毒转染的CAR-T细胞相比,它不具有体内持久性,半衰期短,所以毒副作用也会大大降低。当然,最终还需要通过临床试验对其安全性及疗效做进一步鉴定。
CD44是一组分布广泛的细胞膜糖蛋白,CD44v6是CD44的一个异体蛋白,对AML和骨髓瘤有一定的特异性,但它在正常皮肤上皮细胞也有表达。针对CD44v6 的ADC药物Bivatuzumab mertansine因患者出现致命的表皮坏死松解症于2006年终止研发。以Bivatuzumab scFv 为基础的CAR-T在ALL和多发性骨髓瘤(multiple myeloma,MM)动物模型中疗效显着,并且在体外实验中没有表现出对皮肤上皮细胞的*伤杀**作用,而自杀机制在这个CAR-T项目中的应用,有可能降低其在体内产生的毒副作用。它的CAR-T 临床疗效和CD123, CD33一样有待观察。
Lewis Y抗原(CD174)除神经组织、结缔组织和肌肉组织外,几乎分布于机体所有正常细胞膜。但该抗原在很多血液及实体瘤中过表达,而在正常组织中低表达。CD174 CAR-T细胞在临床试验中的确在肿瘤患处聚集,且没有大的毒副反应,但疗效甚微。尽管如此,CD174 仍是一个极有吸引力的CAR-T靶点,它的下一步应用值得关注。
三、霍奇金淋巴瘤(Hodgkin's lymphoma, HL)
虽然HL起源于B细胞,但HL肿瘤细胞(Hodgkin Reed-Sternberg, HRS)已经丢失了B细胞特异性的表面抗原,且大量表达CD30。CD30属于肿瘤坏死因子受体(TNFR)超家族的细胞表面抗原。在正常情况下,CD30只在一些激活的B细胞和T细胞上表达。识别CD30 的ADC 药物Adcetris (brentuximab vedotin),对复发型的HL有很好的初始疗效,遗憾的是疗效不能持续,大多数病人会再次复发。复发后的HL依然会保持CD30的高表达。但这些病人对Adcetris 二次治疗的有效率远低于初始治疗。考虑到CD30 CAR-T有能力攻击CD30低表达的肿瘤细胞以及它和Adcetris完全不同的治疗机制,CD30 CAR-T将有能力*伤杀**或杀死对Adcetris失去敏感性的肿瘤细胞。CD30 CAR-T的临床试验正在贝勒医学院(Baylor College of Medicine)展开。我们期待看到CD30 CAR-T对HL的治愈性效果。

四、T细胞恶性肿瘤
T细胞恶性肿瘤,主要包括T细胞免疫表型急性淋巴细胞白血病(T-ALL)和T细胞非霍奇金淋巴瘤(T-NHL),它们比B细胞恶性肿瘤更为凶险。随着化疗技术的进步,T细胞肿瘤病人的生存率已有了大幅的提高,但复发几率仍然很大。针对复发型T细胞肿瘤,目前的主要治疗手段是异体造血干细胞移植,找到合适的供体成为病人唯一的希望。而造血干细胞移植迄今仍然是一种高风险治疗方法,因此,开展具有治愈潜质的CAR-T治疗研究意义重大。合适的靶点意味着 CAR-T识别肿瘤T细胞的同时不自我攻击。从表面抗原的角度来讲,可以将这些肿瘤表达的T细胞抗原受体(TCR)作为靶点。但这个方法的缺点显而易见:每个病人的肿瘤特异性TCR不同,而且对CAR-T特异性的要求极高,所以研发的时间长,成本高。也有人提出用CAR-NK治疗T细胞肿瘤,但在没有肿瘤特异性靶点的情况下,T淋巴细胞减少症将会引起可预见的严重毒副反应。目前还没有针对T细胞肿瘤的CAR-T临床试验报道。
多发性骨髓瘤(multiple myeloma,MM)
多发性骨髓瘤(multiple myeloma,MM)是一种恶性浆细胞肿瘤,起源于骨髓中的浆细胞,而浆细胞是B淋巴细胞发育到最终功能阶段的细胞。通常将MM归到B淋巴细胞瘤的范畴。由于MM肿瘤细胞上大部分B细胞标志蛋白表达量极微,甚至不表达,因此针对MM的CAR-T治疗需要寻找新靶点。
CD38分子的表达与分布相当广泛,无细胞系限制性,在定向髓系和淋巴细胞系祖细胞表达水平很高,在NK细胞、T细胞、B细胞等也有表达。有文献报道,与正常浆细胞相比,骨髓瘤细胞CD38的表达明显增加。2015年FDA加速批准了针对CD38的单克隆抗体药物Darzalex(daratumumab)用于MM的治疗。Daratumumab具有广谱*伤杀**活性,靶向结合MM肿瘤细胞表面高表达的跨膜胞外酶CD38分子,可通过多种机制诱导肿瘤细胞的快速凋亡,延长病人的存活期,并且没有严重的髓细胞生长抑制作用。但是,迄今还没有CD38 CAR-T的临床报道。
CD138,又称为syndecan-1,在血液系统中仅表达于浆细胞,是一个浆细胞的标志性抗原,在MM的肿瘤细胞表面高表达。同时,可溶性CD138可以作为浆细胞病特异性指标,能够精确反应恶性浆细胞病的严重程度,在MM中的作用更为明显,它的浓度与骨髓瘤细胞的负荷呈正相关。处在二期临床试验的针对CD138靶点的ADC药物——BT062,与来拉度胺(lenalidomide)联合使用,在MM患者中的应答率可以达到83%。但由于CD138也广泛表达于各类上皮细胞,因此BT062的毒副作用之一就是肝脏和皮肤的毒性反应。可以预见,CD138 CAR-T的类似毒副作用会更显着。
B细胞成熟抗原(B-cell maturation antigen, BCMA)正常表达于成熟的B细胞和浆细胞,在MM中也有广泛的表达,是一个非常理想的免疫治疗靶点。针对BCMA的ADC药物(GSK2857916)和双靶向抗体药物(BI836909)现正处于一期临床和临床前研发过程中。可溶性BCMA在MM病人血清中会升高,且浓度与肿瘤恶性程度呈正相关。但血清中BCMA对免疫治疗的影响还不清楚。针对BCMA的CAR-T 在U Penn, NCI 和 Bluebird Bio 都已进入一期临床试验。
虽然B细胞表面的常见标志蛋白(如CD19, CD20等)不被传统的MM免疫治疗所看好。但是,去年U Penn 和Novartis在NEJM上报道的一个CD19 CAR-T成功治疗MM的病例似乎为这一类抗原带来了新的希望。其文章指出,MM肿瘤细胞中一组抗药性强,增殖能力强(具有肿瘤干细胞特性的)的细胞克隆虽然CD19表达量低,但的确是CD19 阳性的。一例被报道的病例中,尽管99.5%的恶性增生的浆细胞上都缺乏CD19 的表达,该患者依旧获得完全治愈。如果CD19 CAR-T在未来的MM临床实验中,在更多的病人体内证明了其疗效,将是MM治疗的一个重大突破。

针对肿瘤特异性胞内靶点的CAR-T为治愈血液肿瘤带来新希望。
综上所述,科学家在多种血液肿瘤中,都找到了理想的细胞表面抗原靶点,CAR-T治疗血液肿瘤也取得了重大突破。但对于复发型AML,T细胞恶性肿瘤以及某些顽固型B淋巴细胞肿瘤,仍然没有找到理想的细胞表面特异性抗原。
据报道,超过90%的肿瘤特异性抗原都是胞内蛋白或分泌型蛋白。对于血液肿瘤,理想的胞内肿瘤特异性抗原有很多,比如WT1,proteinase 3, RHAMM。以WT1基因(Wilms tumor gene 1)为例,其在正常组织表达量极低,但在绝大部分的AML和ALL中都有极高表达。而且WT1是一种致癌蛋白,它的缺失会抑制肿瘤细胞的生长,因此WT1被公认为是一个理想的肿瘤治疗靶点。然而,传统的抗体介导的肿瘤免疫治疗只能识别细胞表面抗原,对胞内蛋白束手无策。
Eureka Therapeutics开发了能够识别肿瘤特异性胞内蛋白的全人源抗体,并将之与CAR-T技术结合,开发出多个CAR-T药物。以WT1为靶点的全人源抗体ESK1是Eureka Therapeutics开发的第一个识别胞内靶点的抗体药物,其成果已发表在《Science》、《Nature》等多个顶级学术杂志上。我们认为,血液肿瘤的CAR-T治疗的新方向是寻找肿瘤特异性的胞内蛋白或是分泌型蛋白,从而拓展可治疗肿瘤类型。
后续文章中,我们将对使用抗体识别胞内蛋白的原理进行详细阐述。
参考文献
Approaching untargetable tumor-associated antigens with antibodies.
Oncoimmunology. doi: 10.4161/onci.24678 (2013)
DaoT, Liu C and Scheinberg DA.
Reaching un-drugable intracellular targets withthe long arm of antibodies.
Oncotarget. doi: 10.18632/oncotarget.1039 (2013)
David A. Scheinberg, Tao Dao, ChengLiu
Targeting the intracellular WT1 oncogene product with a therapeutichuman antibody.
Science Translational Medicine. Vol. 5, Issue 176, pp. 176ra33.DOI: 10.1126/scitranslmed.3005661 (2013)
T. Dao, S. Yan, N. Veomett, D.Pankov, L. Zhou, T. Korontsvit, A. Scott, J. Whitten, P. Maslak, E. Casey, T.Tan, H. Liu, V. Zakhaleva, M. Curcio, E. Doubrovina, R. J. O'Reilly, C. Liu, D.A. Scheinberg.